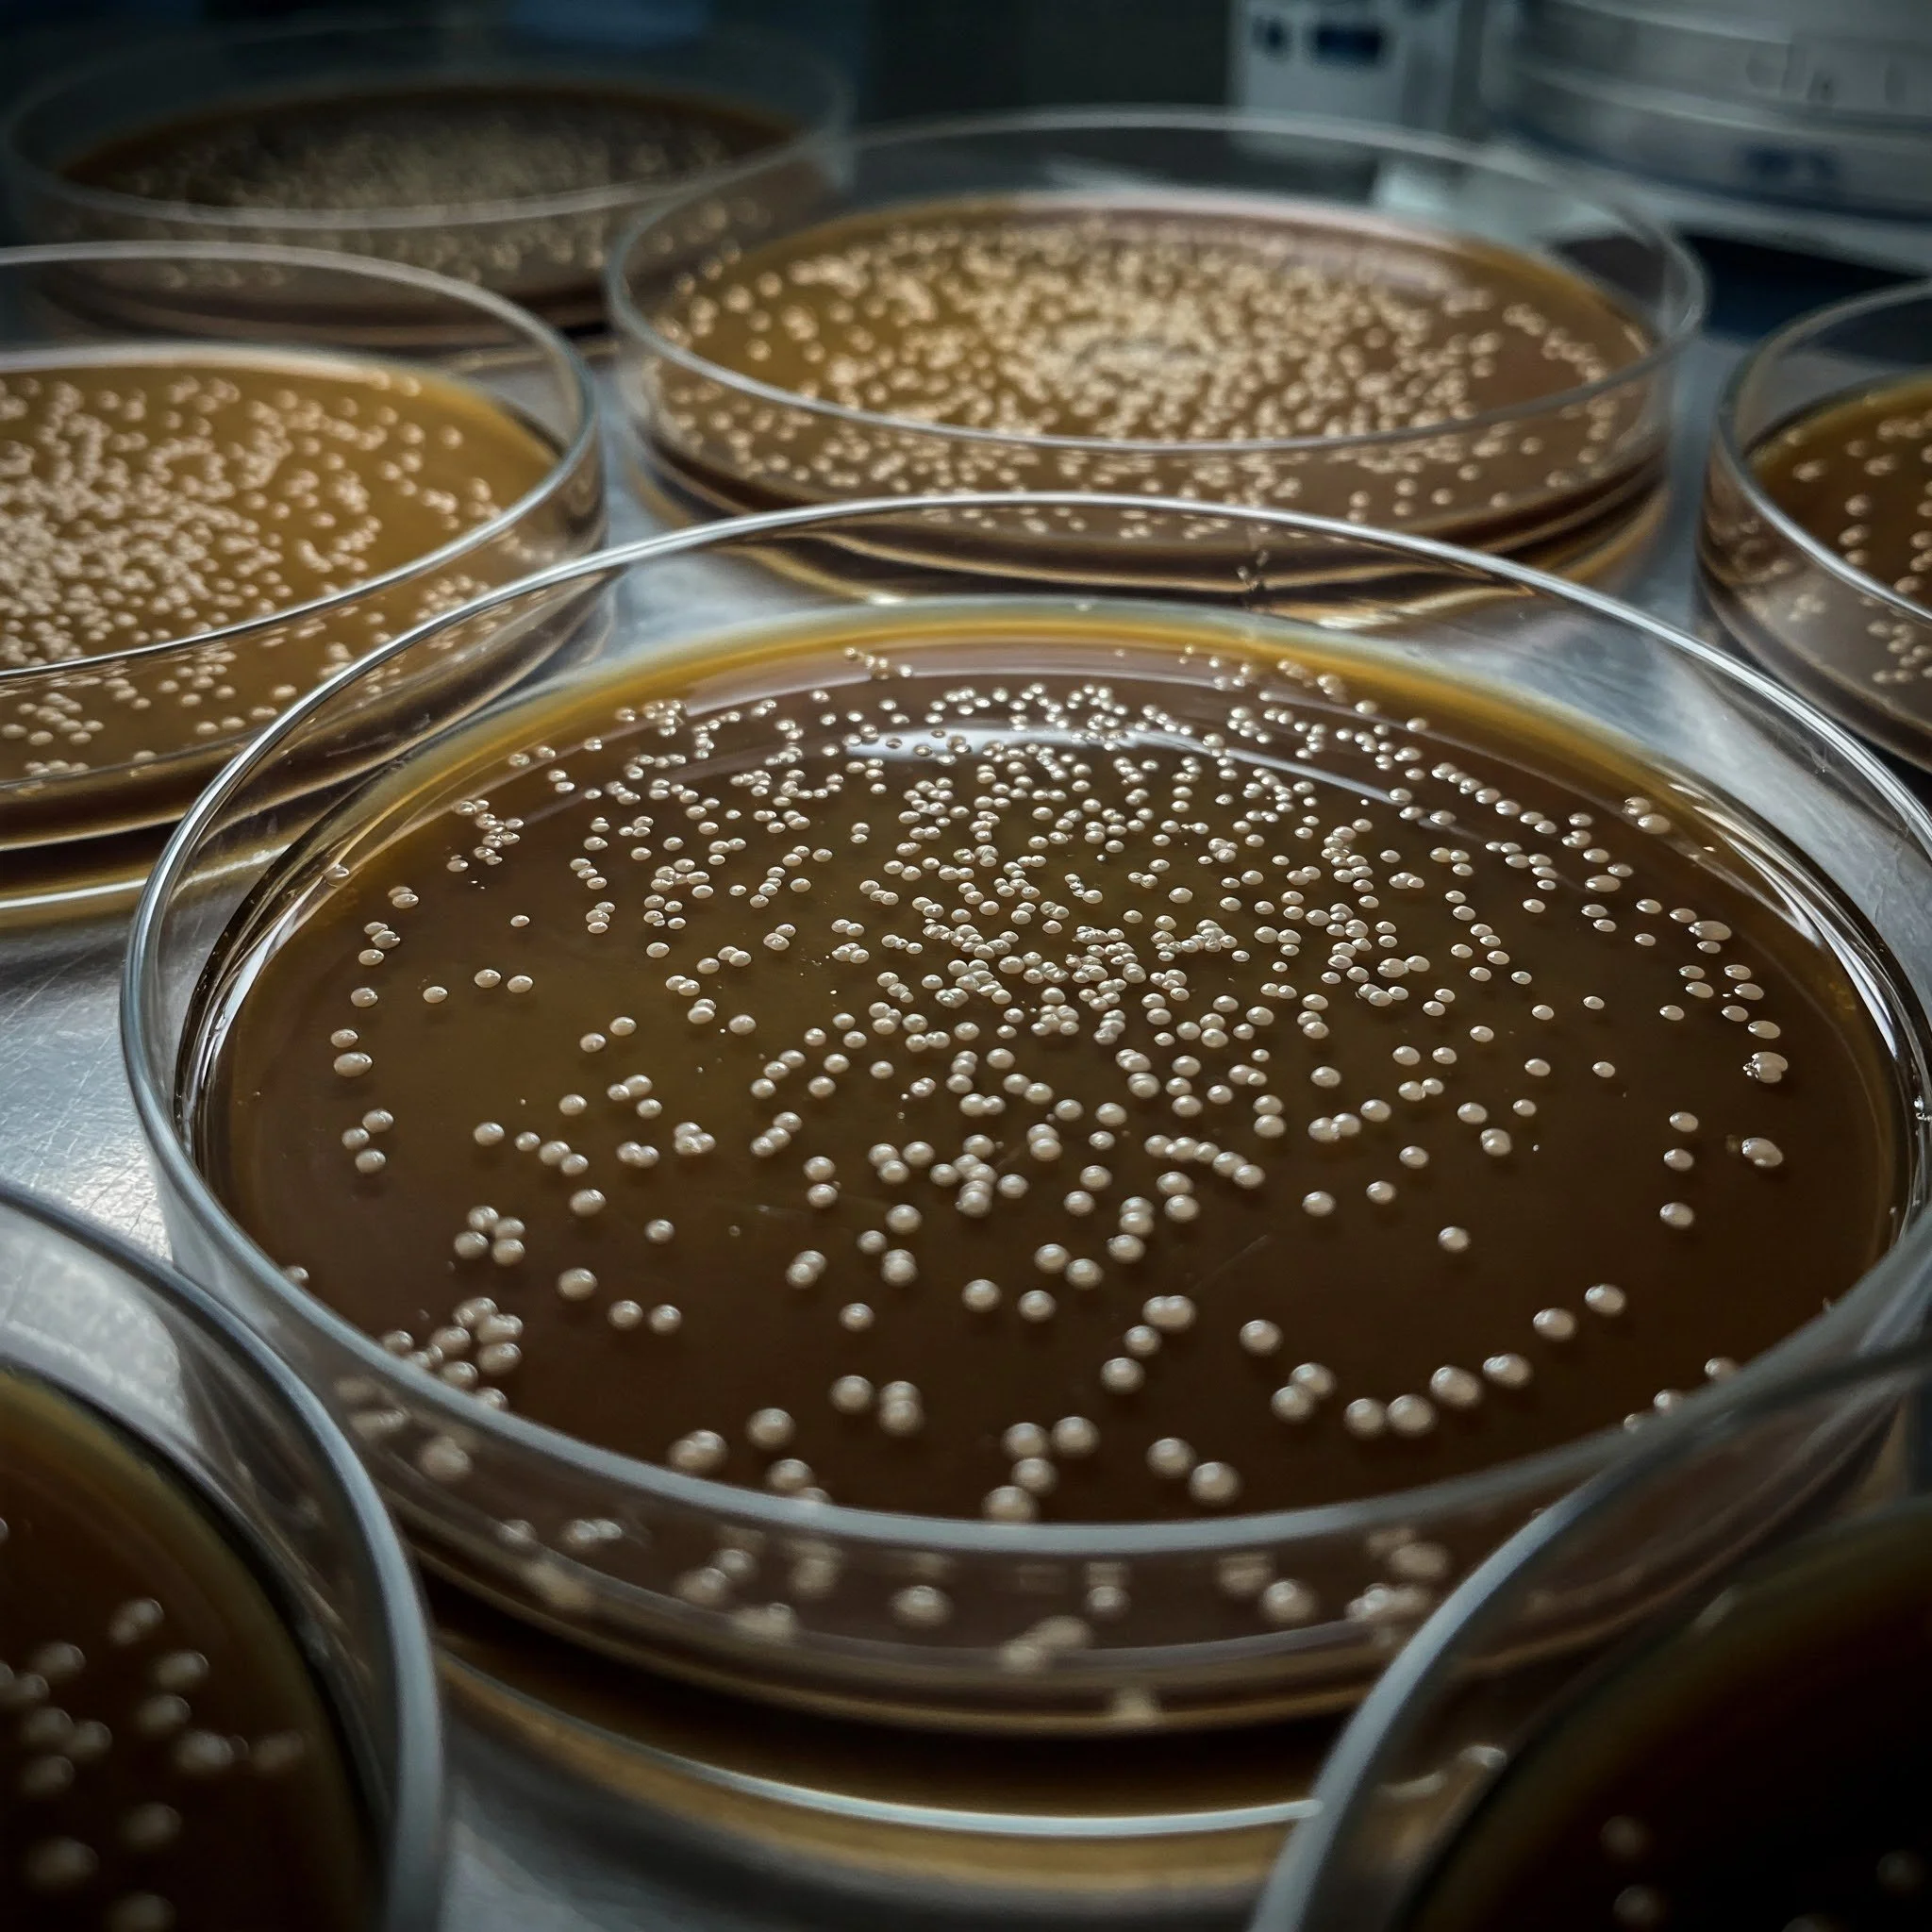
Using biotechnology to lower alcohol in wine

紐西蘭葡萄酒種植者協會 (NZW) 發佈了 紐西蘭葡萄酒2050年淨零碳排放路線圖,目標是使紐西蘭葡萄酒行業在2050年實現淨零碳排放。
Read More我開始好奇便宜的酒是否品質較差。我發現這些酒來自南非,這個國家以生產葡萄酒聞名。他們的著名葡萄酒如Meerlust Rubicon,是按法國波爾多風格釀製的,售價約為288港元。然而,M. Cellars 系列的酒並不是Meerlust Rubicon 相同的級別。
Read More
法國波爾多的1855級莊制度,不是早於1855已經定下來了嗎?最初的時候,Mouton Rothschild並非屬於一級莊。怎麼Mouton Rothschild 可以晉升為一級酒莊?
Read More西班牙雖然平價酒四處見,但酒王當然也有。Vega Sicilla就算不公認為酒王,也很有知名度。
Read More幾年前的美國假酒騙案,假若沒有Domaine Ponsot 的Laurent,恐怕也沒有那麼快把造假事件揭露出來。Domaine Ponsot 的酒引來不法之徒彷製,那必然有原因。這個小酒莊的著名佳釀是什麼?
Read MoreComte Georges de Vogüé 比DRC平宜,但論價錢卻也不是平價的村莊貨色,然而要理解法國人對於釀酒的執著,只要與Francois 傾談,便明白為冷凍浸葡萄的技術是造作和殘酷。
Read More